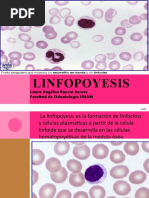

0% encontró este documento útil (0 votos)
393 vistas16 páginasCorriente de Trabert
Este documento describe la corriente ultraexcitante de Trabert, incluyendo sus efectos fisiológicos como contracciones musculares, reducción del dolor y estimulación de la circulación sanguínea. Se aplica aumentando gradualmente la intensidad para evitar la acomodación y reducir el dolor a través de la estimulación de fibras nerviosas. Se usa comúnmente para dolores musculares, radiculares y vasculares.
Cargado por
Alex CervantesDerechos de autor
© © All Rights Reserved
Nos tomamos en serio los derechos de los contenidos. Si sospechas que se trata de tu contenido, reclámalo aquí.
Formatos disponibles
Descarga como PPTX, PDF, TXT o lee en línea desde Scribd
0% encontró este documento útil (0 votos)
393 vistas16 páginasCorriente de Trabert
Este documento describe la corriente ultraexcitante de Trabert, incluyendo sus efectos fisiológicos como contracciones musculares, reducción del dolor y estimulación de la circulación sanguínea. Se aplica aumentando gradualmente la intensidad para evitar la acomodación y reducir el dolor a través de la estimulación de fibras nerviosas. Se usa comúnmente para dolores musculares, radiculares y vasculares.
Cargado por
Alex CervantesDerechos de autor
© © All Rights Reserved
Nos tomamos en serio los derechos de los contenidos. Si sospechas que se trata de tu contenido, reclámalo aquí.
Formatos disponibles
Descarga como PPTX, PDF, TXT o lee en línea desde Scribd